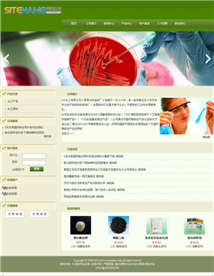

─·║├ŻĪÜgėŁ╣Ō┼R▒▒Š®ÜgėŁ─Ń┐Ų╝╝ėąŽ▐╣½╦Š╣┘ŠW(w©Żng)ŻĪ
╩█Ū░ū╔įā¤ßŠĆŻ║![]() 010-56035709 ▒▒Š®Ąžģ^(q©▒)īŻŠĆŻ║
010-56035709 ▒▒Š®Ąžģ^(q©▒)īŻŠĆŻ║![]() 010-56035709 ╩█║¾Ę■äš(w©┤)īŻŠĆŻ║
010-56035709 ╩█║¾Ę■äš(w©┤)īŻŠĆŻ║![]() 010-56035709 VIPīŻŠĆŻ║
010-56035709 VIPīŻŠĆŻ║![]() 15901551129Ż©24ąĪĢr(sh©¬)Ż®
15901551129Ż©24ąĪĢr(sh©¬)Ż®
- ŠW(w©Żng)šŠ╩ūĒō
HOME - ĻP(gu©Īn)ė┌╬ęéā
ABOUT
▒▒Š®ÜgėŁ─Ń┐Ų╝╝ėąŽ▐╣½╦Š-ųąć°▌^įńĄ─▒▒Š®ŠW(w©Żng)šŠĮ©įO(sh©©)╣½╦ŠŻ╗Å─╩┬▒▒Š®ŠW(w©Żng)šŠĮ©įO(sh©©)Īó▒▒Š®APPķ_░l(f©Ī)Īó▒▒Š®ąĪ│╠ą“ųŲū„Ę■äš(w©┤)Ż╗ČÓ─Ļ▒▒Š®Į©ŠW(w©Żng)šŠĮø(j©®ng)“×(y©żn)Ą─▒▒Š®ŠW(w©Żng)šŠųŲū„╣½╦ŠŻ¼ęčĘ■äš(w©┤)▒▒Š®Į©ŠW(w©Żng)šŠ10000ČÓ╝ęĪŻ▒▒Š®ŠW(w©Żng)šŠųŲū„╣½╦ŠĘ■äš(w©┤)¤ßŠĆŻ║010-56035709
- Ēææ¬(y©®ng)╩ĮŠW(w©Żng)šŠ
HTML5
▒▒Š®ÜgėŁ─Ń┐Ų╝╝ėąŽ▐╣½╦Š-ųąć°▌^įńĄ─▒▒Š®ŠW(w©Żng)šŠĮ©įO(sh©©)╣½╦ŠŻĪ¼F(xi©żn)į┌╩ųÖC(j©®)æ¬(y©®ng)ė├ČÓ,appķ_░l(f©Ī)╚╦åTķ_░l(f©Ī)┴╦öĄ(sh©┤)1000000ėŗ(j©¼)Ą─æ¬(y©®ng)ė├Ż¼╬óą┼ė├æ¶▀^6ā|╚╦,├┐╠ņČ╝ėą╚╦╩╣ė├ęŲäė(d©░ng)×gė[Ų„į┌ŠW(w©Żng)╔Žø_└╦ĪŻ─Ńį┘▓╗ū÷Ēææ¬(y©®ng)╩ĮŠW(w©Żng)šŠŠ═šµĄ─OUT└▓ŻĪ▒▒Š®ŠW(w©Żng)šŠĮ©įO(sh©©)╣½╦ŠļŖįÆŻ║010-56035709
- ░╦║Žę╗ŠW(w©Żng)šŠ
8SITES
▒▒Š®ÜgėŁ─Ń┐Ų╝╝ėąŽ▐╣½╦Š-ųąć°▌^įńĄ─▒▒Š®ŠW(w©Żng)šŠĮ©įO(sh©©)╣½╦Šå¢┤¾╝ęŻ║į┌▒▒Š®Į©ŠW(w©Żng)šŠĖ╔╩▓├┤?ŠW(w©Żng)šŠ╩ŪąĶę¬Įø(j©®ng)ĀIĄ─!▀xō±▒▒Š®ŠW(w©Żng)šŠĮ©įO(sh©©)╣½╦Š║═▒▒Š®APPķ_░l(f©Ī)╣½╦Š┼c▒▒Š®ŠW(w©Żng)šŠ═ŲÅV╣½╦Š×ķę╗¾wĄ─▒▒Š®ŠW(w©Żng)šŠųŲū„╣½╦Š,ūī─·Ą─┐═æ¶ų„äė(d©░ng)šęüĒŻĪ▒▒Š®Į©ŠW(w©Żng)šŠĘ■äš(w©┤)¤ßŠĆŻ║010-56035709
- Ė▀Č╦Č©ųŲ
CUSTOM
▒▒Š®ÜgėŁ─Ń┐Ų╝╝ėąŽ▐╣½╦Š-ųąć°▌^įńĄ─▒▒Š®ŠW(w©Żng)šŠĮ©įO(sh©©)╣½╦ŠŻĪęįąąśI(y©©)ś╦(bi©Īo)£╩(zh©│n)╚źČ©ųŲŠW(w©Żng)šŠŻ¼│╩¼F(xi©żn)į┌┐═æ¶├µŪ░š╣¼F(xi©żn)Ų¾śI(y©©)īŹ(sh©¬)┴”ŻĪČÓ─Ļ▒▒Š®Į©ŠW(w©Żng)šŠĮø(j©®ng)“×(y©żn)Ą─▒▒Š®ŠW(w©Żng)šŠųŲū„╣½╦ŠŻ¼ęčĘ■äš(w©┤)┤¾ąĪŲ¾śI(y©©)10000ČÓ╝ęŻĪ▒▒Š®ŠW(w©Żng)šŠĮ©įO(sh©©)╣½╦ŠĘ■äš(w©┤)¤ßŠĆŻ║010-56035709
- ŠW(w©Żng)šŠ│¼╩ą
SITEMARKET
▒▒Š®ÜgėŁ─Ń┐Ų╝╝ėąŽ▐╣½╦Š-ųąć°▌^įńĄ─▒▒Š®ŠW(w©Żng)šŠĮ©įO(sh©©)╣½╦ŠĮ©šŠŽĄĮy(t©»ng)Ż¼ų╗ę¬Ģ■(hu©¼)┤“ūųŠ═Ģ■(hu©¼)Į©ŠW(w©Żng)šŠŻ¼ĘĮ▒Ń┐ņĮ▌Ż¼▓╗ąĶ꬚Ų╬š┤·┤aų¬ūRŻĪėąČÓ─Ļ▒▒Š®Į©ŠW(w©Żng)šŠĮø(j©®ng)“×(y©żn)Ą─▒▒Š®ŠW(w©Żng)šŠųŲū„╣½╦ŠŻ¼ęčĘ■äš(w©┤)▒▒Š®Į©ŠW(w©Żng)šŠ10000ČÓ╝ęŻĪ▒▒Š®ŠW(w©Żng)šŠųŲū„╣½╦ŠĘ■äš(w©┤)¤ßŠĆŻ║010-56035709
- ā×(y©Łu)╗»═ŲÅV
SEO+SEM
▒▒Š®ÜgėŁ─Ń┐Ų╝╝ėąŽ▐╣½╦Š╚½ŲĮ┼_(t©ói)įŲ═ŲÅVŽĄĮy(t©»ng)Ż¼3-7╠ņīŹ(sh©¬)¼F(xi©żn)10000+ĻP(gu©Īn)µIį~┼┼├¹Ż¼24ąĪĢr(sh©¬)░įš╝Ė„┤¾╦č╦„ę²Ūµ╩ūĒōŻĪ╬ęéā═©▀^┐═æ¶ĻP(gu©Īn)µIį~Ųź┼õĪóAPIī”ĮėŠW(w©Żng)├ĮĪóĘų╬÷Ą╚Ą─ėŗ(j©¼)╦Ń─▄┴”Ż¼║Žū„Ų┌ķg├┐╠ņ╩ūĒōš╣¼F(xi©żn)ĻP(gu©Īn)µIį~1000ĄĮ10000éĆ(g©©)ęį╔ŽŪę┼┼├¹ĘĆ(w©¦n)Č©ĪŻ
- ┬ō(li©ón)ŽĄ╬ęéā
CONTACT
▒▒Š®ÜgėŁ─Ń┐Ų╝╝ėąŽ▐╣½╦Š-ųąć°▌^įńĄ─▒▒Š®ŠW(w©Żng)šŠįO(sh©©)ėŗ(j©¼)╣½╦ŠŻĪÅ─╩┬▒▒Š®ŠW(w©Żng)šŠĮ©įO(sh©©)Ż¼▒▒Š®ŠW(w©Żng)šŠųŲū„Ę■äš(w©┤)│╠Ę■äš(w©┤)Ą─▒▒Š®ŠW(w©Żng)šŠĮ©įO(sh©©)╣½╦ŠŻĪęčĘ■äš(w©┤)▒▒Š®Į©ŠW(w©Żng)šŠ╣½╦Š10000ČÓ╝ęŻĪ▒▒Š®ŠW(w©Żng)šŠĮ©įO(sh©©)╣½╦ŠĘ■äš(w©┤)¤ßŠĆŻ║010-56035709